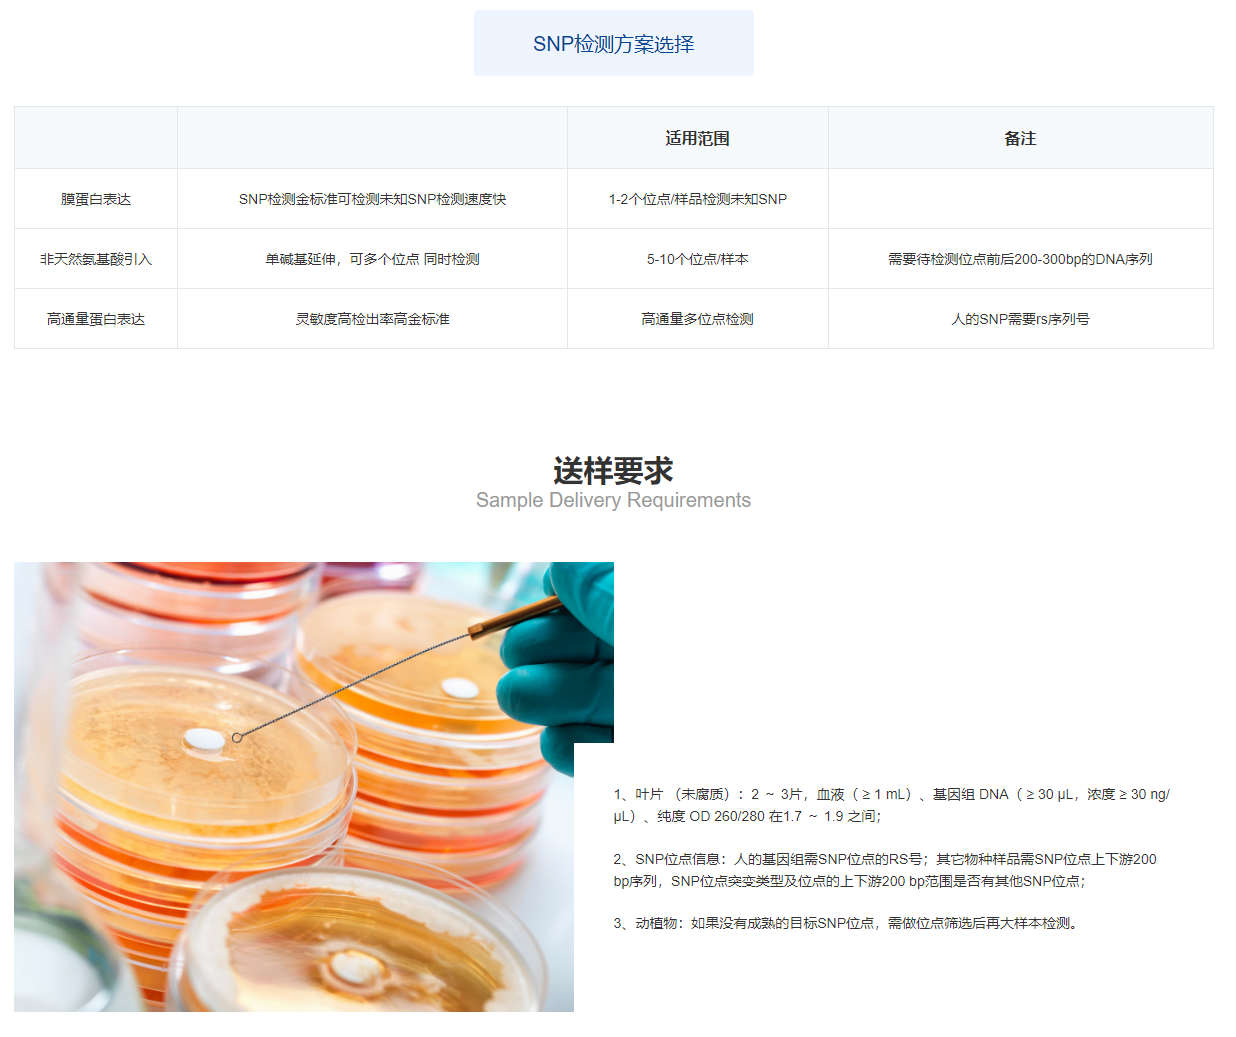

SNP检测
- QK-11
- 擎科
- 北京市
- 一个月内
- 按需定制
- 议价
- 2022-12-01 20:12:53
北京擎科生物科技有限公司
一键申请试用
咨询
加入意向单
联系方式
单核苷酸多态性(Single Nucleotide Polymorphisms,SNP)是指基因组上单个核苷酸的变异,人类基因组平均每1000个就有一个SNP。它是由基因组DNA某一特定核苷酸位置上单个碱基的转换、颠换、插入或缺失引起的点突变,使得群体之间和个体之间产生了差异。其中转换和颠换发生频率较高,转换是指同型碱基之间的转换,即嘌呤与嘌呤、嘧啶与嘧啶间;颠换是指发生在嘌呤与嘧啶之间的替换。
实验方案介绍Introduction to experimental Methods
直接测序法
测序法是检测SNP的金标准,出来检测已知SNP位点,还能发现未知SNP位点,将目标位点PCR扩增后进行测序,根据测序峰图可直观判断 SNP的型别。

Snapshot法

在已知的SNP位点前设计一引物,进行单碱基(带荧光标记)延伸扩增,通过ABI3730仪器检测所延伸的碱基颜色确定SNP位点的型别; 再用软件分析,导出统计结果。

探针法

该方法的技术基础是荧光定量PCR,针对染色体上的不同SNP位点分别设计PCR引物和进行PCR扩增。
这种方法可以直接在实验结果中读取出每个样本中SNP的基因型(纯合子XX活YY,杂合子XY),
不需要再对序列进行分析,具有直观性。
还可以通过软件分析出不同基因型在所有样本中的分布图。TaqMan探针法通常用于少量SNP位点分析,具有成本低、速度快的特点。